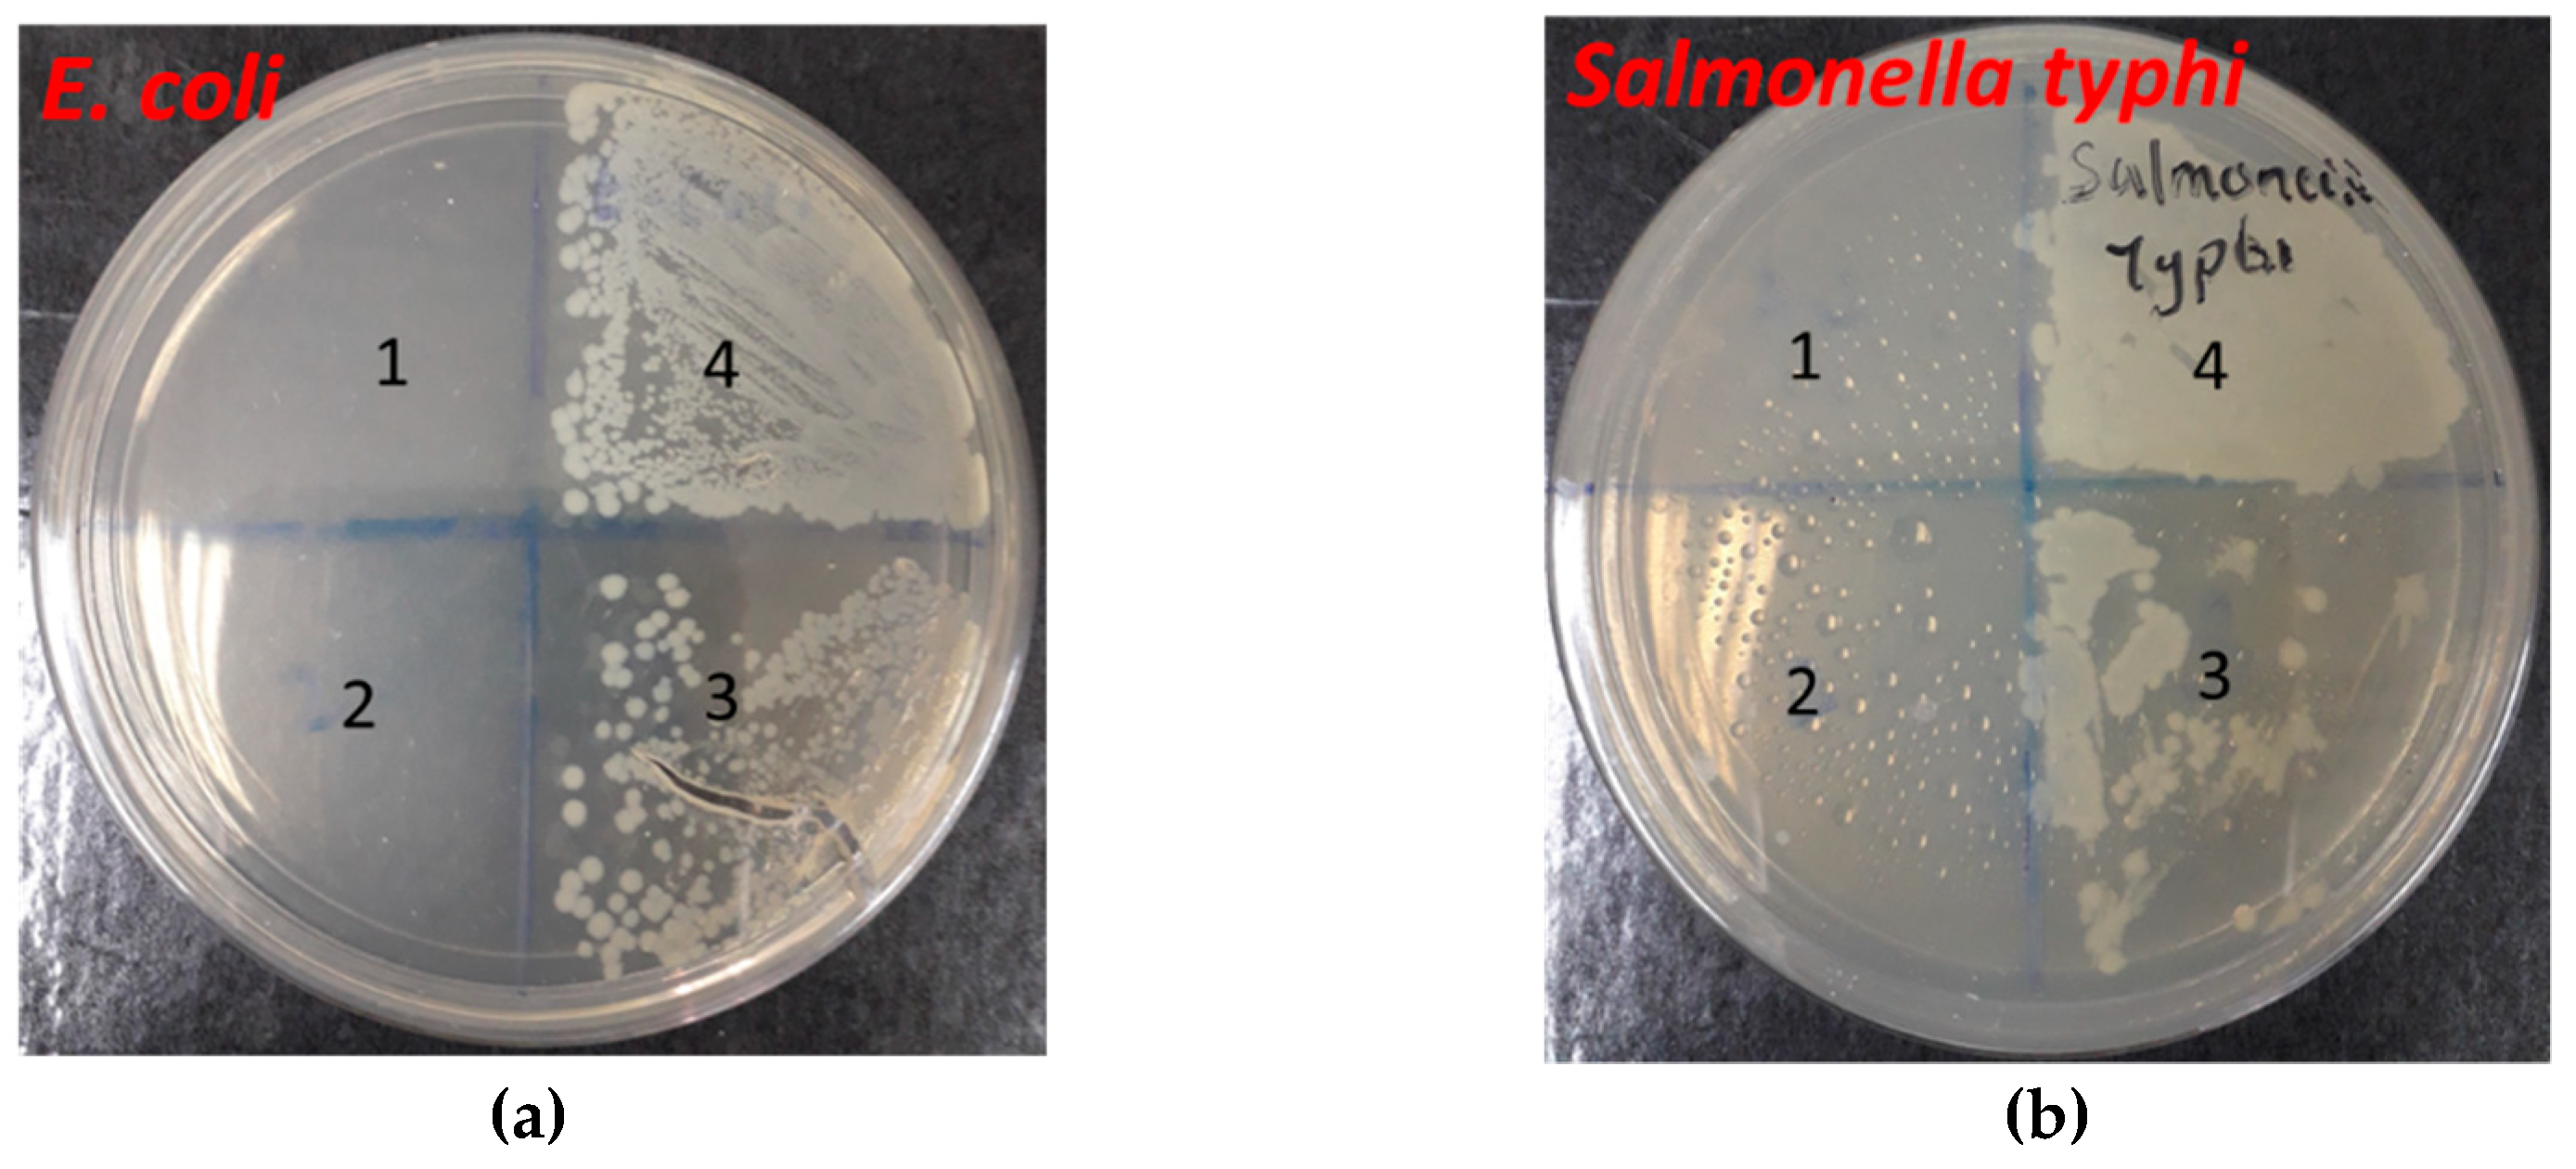

Chemical Profile, Antioxidant Properties and Antimicrobial Activities of Malaysian Heterotrigona itama Bee Bread
Abstract
1. Introduction
2. Results
2.1. pH of Heterotrigona itama Bee Bread
2.2. Phytochemical Screening Analysis of Heterotrigona itama Bee Bread
2.3. Analysis of In Vitro Antioxidant Assessment of Heterotrigona itama Bee Bread
2.3.1. DPPH Radical and H2O2 Scavenging Activities of Heterotrigona itama Bee Bread
2.3.2. Total Phenolic and Flavonoid Contents of Heterotrigona itama Bee Bread
2.3.3. Ferric Ion-Reducing Antioxidant Power (FRAP) of Heterotrigona itama Bee Bread
2.3.4. Phenolic Compounds Analysis of BBE Using High-Performance Liquid Chromatography (HPLC)
2.4. Antimicrobial Activities of Heterotrigona itama Bee Bread
3. Discussion
4. Materials and Methods
4.1. Collection and Preparation of Heterotrigona itama Bee Bread
4.2. Preparation of Heterotrigona itama Bee Bread
4.3. pH of Heterotrigona itama Bee Bread
4.4. Phytochemical Screening of Heterotrigona itama Bee Bread
4.5. In Vitro Antioxidant Property of Heterotrigona itama Bee Bread
4.5.1. DPPH Radical Scavenging Activity
4.5.2. Ferric Reducing Antioxidant Power
4.5.3. Hydrogen Peroxide Scavenging Activity
4.5.4. Total Phenolic Content
4.5.5. Total Flavonoid Content
4.6. Determination of the Antimicrobial Activity of Heterotrigona itama Bee Bread
4.6.1. Minimum Inhibitory Concentration (MIC) Determination
4.6.2. Disc Diffusion Assay
4.6.3. Broth Dilution Method
4.7. High-Performance Liquid Chromatography (HPLC) Analysis of Heterotrigona itama Bee Bread
4.8. Statistical Analysis
5. Conclusions
Author Contributions
Funding
Institutional Review Board Statement
Informed Consent Statement
Data Availability Statement
Acknowledgments
Conflicts of Interest
Sample Availability
References
- Disayathanoowat, T.; Li, H.; Supapimon, N.; Suwannarach, N.; Lumyong, S.; Chantawannakul, P.; Guo, J. Different Dynamics of Bacterial and Fungal Communities in Hive-Stored Bee Bread and Their Possible Roles: A Case Study from Two Commercial Honey Bees in China. Microorganisms 2020, 8, 264. [Google Scholar] [CrossRef] [PubMed]
- Nagai, T.; Nagashima, T.; Myoda, T.; Inoue, R. Preparation and Functional Properties of Extracts from Bee Bread. Mol. Nutr. Food Res. 2004, 48, 226–229. [Google Scholar] [CrossRef] [PubMed]
- Ahmed, S.; Sulaiman, S.A.; Baig, A.A.; Ibrahim, M.; Liaqat, S.; Fatima, S.; Jabeen, S.; Shamim, N.; Othman, N.H. Honey as a Potential Natural Antioxidant Medicine: An Insight into Its Molecular Mechanisms of Action. Oxidative Med. Cell. Longev. 2018, 2018, 1–19. [Google Scholar] [CrossRef] [PubMed]
- Janashia, I.; Choiset, Y.; Józefiak, D.; Déniel, F.; Coton, E.; Moosavi-Movahedi, A.A.; Chanishvili, N.; Haertlé, T. Beneficial Protective Role of Endogenous Lactic Acid Bacteria Against Mycotic Contamination of Honeybee Beebread. Probiotics Antimicrob. Proteins 2018, 10, 638–646. [Google Scholar] [CrossRef] [PubMed]
- Komosinska-Vassev, K.; Olczyk, P.; Kaźmierczak, J.; Mencner, L.; Olczyk, K. Bee Pollen: Chemical Composition and Therapeutic Application. Evid. Based Complement. Altern. Med. 2015, 2015, 1–6. [Google Scholar] [CrossRef]
- Mărgăoan, R.; Stranț, M.; Varadi, A.; Topal, E.; Yücel, B.; Cornea-Cipcigan, M.; Campos, M.G.; Vodnar, D.C. Bee Collected Pollen and Bee Bread: Bioactive Constituents and Health Benefits. Antioxidants 2019, 8, 568. [Google Scholar] [CrossRef] [PubMed]
- Paramás, A.M.G.; Bárez, J.A.G.; Marcos, C.C.; García-Villanova, R.J.; Sánchez, J.S. HPLC-Fluorimetric Method for Analysis of Amino Acids in Products of the Hive (Honey and Bee-Pollen). Food Chem. 2006, 95, 148–156. [Google Scholar] [CrossRef]
- Andjelkovic, B.; Jevtic, G.; Markovic, J.; Mladenovic, M.; Pseva, V. Quality of Honey Bee Bread Collected in Spring. Proc. Int. Symp. Anim. Sci. 2015, 1, 450–454. [Google Scholar]
- Stanciu, O.; Marghitas, L.A.; Dezmirean, D. Examination of Antioxidant Capacity of Beebread Extracts by Different Complementary Assays. Bull. USAMV-CN 2007, 63, 1–4. [Google Scholar]
- Kaplan, M.; Karaoglu, Ö.; Eroglu, N.; Silici, S. Fatty Acid and Proximate Composition of Bee Bread. Food Technol. Biotechnol. 2016, 54, 497. [Google Scholar] [CrossRef]
- Stanciu, O.; Marghitas, L.-A.; Dezmirean, D. Macro-and Oligo-Mineral Elements from Honeybee-Collected Pollenand Beebread Harvested from Transylvania (Romania). Bull. Univ. Agric. Sci. Vet. Med. Cluj-Napoca. Anim. Sci. Biotechnol. 2009, 66, 1–2. [Google Scholar]
- Ahuja, A.; Ahuja, V. Apitherapy–A Sweet Approach to Dental Diseases-Part I: Honey. J. Adv. Dent. Res. I 2010, 1, 81–86. [Google Scholar]
- Zerdani, I.; Abouda, Z.; Kalalou, I.; Faid, M.; Ahami, M. The Antibacterial Activity of Moroccan Bee Bread and Bee-Pollen (Fresh and Dried) against Pathogenic Bacteria. Res. J. Microbiol. 2011, 6, 376–384. [Google Scholar] [CrossRef]
- Tichý, J.; Novak, J. Detection of Antimicrobials in Bee Products with Activity against Viridans Streptococci. J. Altern. Complement. Med. 2000, 6, 383–389. [Google Scholar] [CrossRef]
- Bogdanov, S. Functional and Biological Properties of the Bee Products: A Review. Bee Prod. Sci. 2011, 1, 1–12. [Google Scholar]
- Estevinho, M.L.M.F.; Rodrigues, S.S.Q.; Pereira, A.P.; Feás, X. Portuguese Bee Pollen: Palynological Study, Nutritional and Microbiological Evaluation. Int. J. Food Sci. Technol. 2011, 47, 429–435. [Google Scholar] [CrossRef]
- Hider, R.C. Honeybee Venom: A Rich Source of Pharmacologically Active Peptides. Endeavour 1988, 12, 60–65. [Google Scholar] [CrossRef]
- Gómez-Caravaca, A.M.; Romero, M.G.; Arraez-Roman, D.; Segura-Carretero, A.; Gutierrez, A.F. Advances in the Analysis of Phenolic Compounds in Products Derived from bees. J. Pharm. Biomed. Anal. 2006, 41, 1220–1234. [Google Scholar] [CrossRef] [PubMed]
- Imran, M.; Salehi, B.; Sharifi-Rad, J.; Gondal, T.A.; Saeed, F.; Imran, A.; Shahbaz, M.; Fokou, P.V.T.; Arshad, M.U.; Khan, H.; et al. Kaempferol: A Key Emphasis to Its Anticancer Potential. Molecules 2019, 24, 2277. [Google Scholar] [CrossRef] [PubMed]
- Orsolic, N. Possible Molecular Targets of Bee Venom in the Treatment of Cancer: Application and Perspectives. Forum Immunopathol. Dis. Ther. 2013, 4, 275–315. [Google Scholar] [CrossRef]
- Othman1, Z.A.; Noordin, L.; Ghazali, W.S.W.; Omar, N.; Mohamed, M. Nutritional, Phytochemical and Antioxidant Analysis of Bee Bread from Different Regions of Malaysia. Indian J. Pharm. Sci. 2019, 81, 955–960. [Google Scholar] [CrossRef]
- Eleazu, C.; Suleiman, J.B.; Othman, Z.A.; Zakaria, Z.; Nna, V.U.; Hussain, N.H.N.; Mohamed, M. Bee Bread Attenuates High Fat Diet Induced Renal Pathology in Obese Rats via Modulation of Oxidative stress, Downregulation of NF-kB Mediated Inflammation and Bax Signalling. Arch. Physiol. Biochem. 2020, 1–17. [Google Scholar] [CrossRef]
- Vásquez, A.; Olofsson, T.C. The Lactic Acid Bacteria Involved in the Production of Bee Pollen and Bee Bread. J. Apic. Res. 2009, 48, 189–195. [Google Scholar] [CrossRef]
- DeGrandi-Hoffman, G.; Eckholm, B.; Huang, M.H. A Comparison of Bee Bread made by Africanized and European Honey Bees (Apis Mellifera) and its Effects on Hemolymph Protein Titers. Apidologie 2012, 44, 52–63. [Google Scholar] [CrossRef]
- Aylanc, V.; Falcão, S.I.; Ertosun, S.; Vilas-Boas, M. From the Hive to the Table: Nutrition Value, Digestibility and Bioavailability of the Dietary Phytochemicals Present in the Bee Pollen and Bee Bread. Trends Food Sci. Technol. 2021, 109, 464–481. [Google Scholar] [CrossRef]
- Akhir, R.A.M.; Abu Bakar, M.F.; Sanusi, S.B. Antioxidant and Antimicrobial Activity of Stingless Bee Bread and Propolis. Extracts 2017. [Google Scholar] [CrossRef]
- Baltrušaitytė, V.; Venskutonis, P.R.; Čeksterytė, V. Radical Scavenging Activity of Different Floral Origin Honey and Beebread Phenolic Extracts. Food Chem. 2007, 101, 502–514. [Google Scholar] [CrossRef]
- Isidorov, V.; Isidorova, A.; Sczczepaniak, L.; Czyżewska, U. Gas Chromatographic–Mass Spectrometric Investigation of the Chemical Composition of Beebread. Food Chem. 2009, 115, 1056–1063. [Google Scholar] [CrossRef]
- Tavdidishvili, D.; Khutsidze, T.; Pkhakadze, M.; Vanidze, M.; Kalandia, A. Flavonoids in Georgian Bee Bread and Bee Pollen. J. Chem. Chem. Eng. 2014, 8, 676–681. [Google Scholar]
- Sobral, F.; Calhelha, R.C.; Barros, L.; Dueñas, M.; Tomás, A.; Santos-Buelga, C.; Vilas-Boas, M.; Ferreira, I.C.F.R. Flavonoid Composition and Antitumor Activity of Bee Bread Collected in Northeast Portugal. Molecules 2017, 22, 248. [Google Scholar] [CrossRef]
- Bakour, M.; Fernandes, Â.; Barros, L.; Sokovic, M.; Ferreira, I.C. Bee bread as a functional product: Chemical Composition and Bioactive Properties. LWT 2019, 109, 276–282. [Google Scholar] [CrossRef]
- Urcan, A.C.; Criste, A.D.; Dezmirean, D.S.; Mărgăoan, R.; Caeiro, A.; Campos, M.G. Similarity of Data from Bee Bread with the Same Taxa Collected in India and Romania. Molecules 2018, 23, 2491. [Google Scholar] [CrossRef] [PubMed]
- Ivanišová, E.; Kačániová, M.; Frančáková, H.; Petrová, J.; Hutková, J.; Brovarskyi, V.; Velychko, S.; Adamchuk, L.; Schubertová, Z.; Musilová, J. Bee Bread-Perspective Source of Bioactive Compounds for Future. Potravin. Slovak J. Food Sci. 2015, 9, 592–598. [Google Scholar] [CrossRef]
- Borycka, K.; Grabek-Lejko, D.; Kasprzyk, I. Antioxidant and Antibacterial Properties of Commercial Bee Pollen Products. J. Apic. Res. 2015, 54, 491–502. [Google Scholar] [CrossRef]
- Raaman, N. Phytochemical Techniques; New India Publishing: Delhi, India, 2006. [Google Scholar]
- Ajayi, G.; Olagunju, J.; Ademuyiwa, O.; Martins, O. Gas Chromatography-Mass Spectrometry Analysis and Phytochemical Screening of Ethanolic Root Extract of Plumbago Zeylanica. Linn. J. Med. Plant. Res. 2011, 5, 1756–1761. [Google Scholar]
- Ganesh, S.; Vennila, J.J. Phytochemical Analysis of Acanthus Ilicifolius and Avicennia Officinalis by GC-MS. Res. J. Phytochem. 2011, 5, 60–65. [Google Scholar] [CrossRef]
- Oršolić, N.; Sirovina, D.; Končić, M.Z.; Lacković, G.; Gregorović, G. Effect of Croatian Propolis on Diabetic Nephropathy and Liver Toxicity in Mice. BMC Complement. Altern. Med. 2012, 12, 117. [Google Scholar] [CrossRef] [PubMed]
- Benzie, I.F.; Strain, J. Ferric Reducing/Antioxidant Power Assay: Direct Measure of Total Antioxidant Activity of Biological Fluids and Modified Version for Simultaneous Measurement of Total Antioxidant Power and Ascorbic Acid. Concentration 1999, 299, 15–27. [Google Scholar] [CrossRef]
- Gülçın, İ.; Oktay, M.; Kıreçcı, E.; Küfrevıoǧlu, Ö.İ. Screening of Antioxidant and Antimicrobial Activities of Anise (Pimpinella Anisum, L.) Seed Extracts. Food Chem. 2003, 83, 371–382. [Google Scholar] [CrossRef]
- Marigo, G. On a Fractionation Method and Estimation of the Phenolic Compounds in Plants. Analysis 1973, 2, 106–110. [Google Scholar]
- El Hariri, B.; Sallé, G.; Andary, C. Involvement of Flavonoids in the Resistance of Two Poplar Cultivars to Mistletoe (Viscum Album L.). Protoplasma 1991, 162, 20–26. [Google Scholar] [CrossRef]
- Ezeigbo, O.; Nwachukwu, I.; Ike-Amadi, C.; Suleiman, J. Evaluation of the Phytochemical, Proximate and Mineral Constituents of Breynia nivosa Leaf. Int. J. Biochem. Res. Rev. 2017, 20, 1–8. [Google Scholar] [CrossRef]
- Chen, S.C.A.; O’Donnell, M.L.; Gordon, S.; Gilbert, G.L. Antifungal Susceptibility Testing using the E Test: Comparison with the Broth Macrodilution Technique. J. Antimicrob. Chemother. 1996, 37, 265–273. [Google Scholar] [CrossRef] [PubMed][Green Version]

| Compound | BBE | BBW | BBH |
|---|---|---|---|
| Phenols | ++ | + | + |
| Glycosides | ++ | + | + |
| Alkaloids | ++ | + | + |
| Xanthoproteins | + | + | + |
| Terpenoids | +++ | + | ++ |
| Tannins | + | + | + |
| Resins | ++ | + | ++ |
| Saponins | ++ | ++ | ++ |
| Flavonoids | +++ | + | ++ |
| Parameter | BBE | BBW | BBH |
|---|---|---|---|
| DPPH radical scavenging activity (%) | 85.79 ± 0.40 | 7.62 ± 0.13 a | 8.47 ± 0.01 a,b |
| Hydrogen peroxide scavenging activity (%) | 90.53 ± 2.14 | 74.21 ± 1.61 | 69.61 ± 0.98 a,b |
| FRAP (µmol Fe2+ Eq/L) | 106.7 ± 1.47 | 68.49 ± 0.94 a | 48.59 ± 1.95 a,b |
| Total phenolic content (mg GAE g−1) | 17.44 ± 0.93 | 9.80 ± 0.10 a | 9.55 ± 1.00 a |
| Total flavonoid content (mg QE g−1) | 21.34 ± 0.83 | 2.69 ± 0.09 a | 4.82 ± 0.37 a,b |
Publisher’s Note: MDPI stays neutral with regard to jurisdictional claims in published maps and institutional affiliations. |
© 2021 by the authors. Licensee MDPI, Basel, Switzerland. This article is an open access article distributed under the terms and conditions of the Creative Commons Attribution (CC BY) license (https://creativecommons.org/licenses/by/4.0/).
Share and Cite
Suleiman, J.B.; Mohamed, M.; Abu Bakar, A.B.; Nna, V.U.; Zakaria, Z.; Othman, Z.A.; Aroyehun, A.B. Chemical Profile, Antioxidant Properties and Antimicrobial Activities of Malaysian Heterotrigona itama Bee Bread. Molecules 2021, 26, 4943. https://doi.org/10.3390/molecules26164943
Suleiman JB, Mohamed M, Abu Bakar AB, Nna VU, Zakaria Z, Othman ZA, Aroyehun AB. Chemical Profile, Antioxidant Properties and Antimicrobial Activities of Malaysian Heterotrigona itama Bee Bread. Molecules. 2021; 26(16):4943. https://doi.org/10.3390/molecules26164943
Chicago/Turabian StyleSuleiman, Joseph Bagi, Mahaneem Mohamed, Ainul Bahiyah Abu Bakar, Victor Udo Nna, Zaida Zakaria, Zaidatul Akmal Othman, and Abdulqudus Bola Aroyehun. 2021. "Chemical Profile, Antioxidant Properties and Antimicrobial Activities of Malaysian Heterotrigona itama Bee Bread" Molecules 26, no. 16: 4943. https://doi.org/10.3390/molecules26164943
APA StyleSuleiman, J. B., Mohamed, M., Abu Bakar, A. B., Nna, V. U., Zakaria, Z., Othman, Z. A., & Aroyehun, A. B. (2021). Chemical Profile, Antioxidant Properties and Antimicrobial Activities of Malaysian Heterotrigona itama Bee Bread. Molecules, 26(16), 4943. https://doi.org/10.3390/molecules26164943










